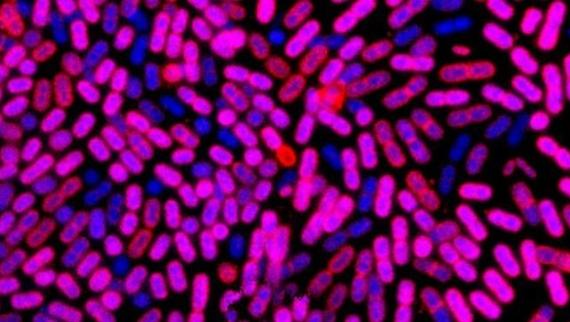
Bacterias ao microscopio con tinción gram (púrpura e azul)

Nutrition and Human Health
Seafood is a key component of a healthy diet. The generally high nutritional quality of seafood is not only associated with protein contribution, but also largely relates to its content of PUFAs, particularly omega-3 fatty acids, as well as to a range of essential micronutrients.
Fish intake has been associated with reduced risk of cardiovascular disease. There is also some evidence that fish consumption is related to reduced risks of type-2 diabetes, impaired cognitive function and neurodevelopmental alterations in the fetus and in young children. The growing awareness of the relationship between health and diet, together with advances in food analytics, nutrition-based diseases and -omic tools, have given rise to a new demand from consumers: personalized or precision nutrition products for target audiences.
However, nutrient contents differ depending on how seafood is produced, processed, prepared and consumed. Nutritional value is highly variable and depends on the species, the season and the product's origin. Although fish meals are being continuously improved, farmed fish usually show poorer nutritional profiles than wild fish because of differences in their diet. Nutritional quality is also affected by post-harvest handling, processing, transport and packaging. Conservation techniques also influence the preservation of their original nutritional value. Traceability becomes again crucial to guarantee product quality and avoid food fraud.
While the nutritional value of fish is well recognized, there are also some concerns related to its consumption, such as the increasing appearance of seafood allergies and intolerances, as well as indirect risks related to emerging contaminants or the development of antimicrobial resistances.
The IIM-CSIC has a long experience in developing innovations together with the food industry to advance on all these challenges. You can read about all our capabilities and associated services below.
Capabilities
- Patent | Myticin peptide and its use in cell regeneration
Authors: Antonio Figueras Huerta, María Gasset Vega, Beatriz Novoa García, Magalí Rey Campos, Ricardo Mallavía Marín, Regla María Medina Gali, Alicia Martínez López
The present invention relates to peptides derived from myticin C and to their therapeutic use, more specifically in cell and/or tissue regeneration. More detailed information can be obtained here.
- Patent | Andrographolide derivatives for their use in the treatment of cytokine-related inflammatory diseases
Authors: Eva María Rivero Buceta; Cristian Smerdou Picazo; Pablo Botella Asunción; Antonio Pineda Lucena; Carla María Vidaurre Agut; Beatriz Novoa; Antonio Figueras Huertas; Jose María Benlloch Baviera
Andrographolide derivatives for their use in the treatment of cytokine-related inflammatory diseases . Patent pending publication.
- Patent | Andrographolide derivatives for their use in the treatment of COVID-19 and associated pulmonary fibrosis
Authors: Antonio Pineda Lucena; Carla María Vidaurre Agut; Eva María Rivero Buceta; Jose María Benlloch Baviera; Cristian Smerdou Picazo; Beatriz Novoa; Antonio Figueras Huertas; Pablo Botella Asunción
Andrographolid derivatives for their use in the treatment of COVID-19 and associated pulmonary fibrosis. Patent pending publication.
- Patent | Alkyl gallate derivatives as antioxidant and surfactant agents
Authors: Juan Carlos Morales Sánchez, Ricardo Lucas Rodriguez, Olivia Sánchez Maldonado, Francesc Comelles Folch, José Luis Parra Juez, Isabel Medina Méndez
The invention relates to a compound derived from an alkyl gallate and its production method and to its use as a surfactant and oxidizing agent, in particular as part of a composition in the form of an emulsion. More detailed information can be obtained here.
- Patent | Compounds having anti-inflammatory activity
Authors: Juan Carlos Espin de Gea; Juan Carlos Morales Sánchez; Isabel Medina
Compounds for the treatment of inflammatory processes involved in numerous diseases such as intestinal inflammatory diseases. The invention mainly refers to compounds included within a certain general formula and to the procedure to obtain them. More detailed information can be obtained here.
Active projects
- BIOTRANSFER -
<p>Polymicrobial L. monocytogenes-carrying biofilms as a key on the risk of listeriosis in foods</p>
Principal investigator:LópezCaboMartaFunding body:CSICFunding for IIM-CSIC:28557€Go to project pageFromto <p>Determinación de la calidad sensorial y química de especies marinas refrigeradas conservadas en distintos tipos de envases</p>
Principal investigator:AubourgMartínezSantiago PedroFunding body:CETMARFunding for IIM-CSIC:10145€Go to project pageFromto- SEAFOOD-ID -
<p>ANALYTICAL STRATEGIES BASED ON NON-DESTRUCTIVE METHODS AND METAGENOMICS FOR THE CONTROL OF PRODUCTION METHOD AND GEOGRAPHIC ORIGIN</p>
Principal investigator:GonzálezSoteloCarmenPérezMartínRicardo IsaacFunding body:Proyecto PID2020-118012RB-C21 financiado por MCIN/ AEI /10.13039/501100011033Funding for IIM-CSIC:168000€Go to project pageFromto - Contrato Programa -
<p>AYUDA CONVENIO ENTRE CSIC Y LA AXENCIA GALEGA DE INNOVACIÓN -GAIN- PARA EL DESARROLLO DE PROGRAMAS DE I+D+i EN LOS INSTITUTOS DE INVESTIGACIÓN DEL CSIC EN GALICIA Y EN LOS CENTROS OCEANOGRÁFICOS DEL INSTITUTO ESPAÑOL DE OCEANOGRAFÍA (CSIC-IEO). 2021-2022</p>
Principal investigator:SaboridoReyFranFunding body:Agencia Galega de InnovaciónFunding for IIM-CSIC:521824€Go to project pageFromto - ANIBLOCK_ANICHAIN -
<p>Investigación sobre párasitos del pescado, principalmente anisakis y otros.</p>
Principal investigator:GonzálezGonzálezÁngel FranciscoFunding body:MERCADONA SAFunding for IIM-CSIC:41013€Go to project pageFromto <p>Investigación sobre párasitos del pescado, principalmente anisakis y otros.</p>
Principal investigator:GonzálezGonzálezÁngel FranciscoFunding body:MERCADONA SAFunding for IIM-CSIC:33221€Go to project pageFromto- ISEAS -
<p>Nanopartículas con hidrolizados de colágeno marino: aplicaciones en cosmética</p>
Principal investigator:PérezMartínRicardo IsaacFunding body:CSICFunding for IIM-CSIC:52000€Go to project pageFromto - ResiduoZero_2 -
<p>Residuo Zero: Puesta en marcha de una planta piloto par ala transformación y elaboración de nuevos productos procedentes de la transformación de dorada y lubina Culmárex y en los planes de etiquetado de nuevos Productos.</p>
Principal investigator:MedinaMéndezIsabelFunding body:Culmarex S.A.Funding for IIM-CSIC:24705€Go to project pageFromto - BBM -
<p>Biotecnología y Bioprocesos Marinos</p>
Principal investigator:GonzálezSoteloCarmenFunding body:Ayudas cofinanciadas con fondos de la Agencia Gallega de Innovación de la Xunta de GaliciaFunding for IIM-CSIC:75000€Go to project pageFromto - ARMAS -
<p>Estudio, diseño e implementación de estrategias de Análisis de riesgos para fortalecer las seguridad, calidad y calidez del Rape y la Merluza del Atlántico Sudeste frente a parásitos zoonóticos</p>
Principal investigator:GonzálezGonzálezÁngel FranciscoFunding body:Mascato SAFunding for IIM-CSIC:88417€Go to project pageFromto